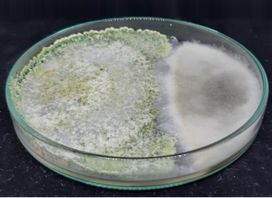

Nuestro servicio de ensayo permite evaluar el comportamiento y las propiedades de diversos materiales bajo condiciones específicas. Mediante pruebas especializadas, garantizamos resultados precisos que ayudan en la toma de decisiones para optimizar procesos, mejorar la calidad y cumplir con normativas exigentes en distintas industrias.
Los ensayos de eficacia son pruebas científicas diseñadas para evaluar el rendimiento de productos destinados al control de plagas, enfermedades y nutrición vegetal. Estos estudios permiten validar la efectividad de bioinsumos, extractos vegetales y agroquímicos en condiciones controladas y de campo, asegurando su desempeño en diferentes cultivos y ambientes.
A través de metodologías rigurosas y protocolos estandarizados, se analizan factores como la dosis óptima, el modo de aplicación, la persistencia y la compatibilidad con otros tratamientos agrícolas. Los resultados obtenidos proporcionan información clave para la toma de decisiones, el desarrollo de nuevos productos y la certificación de su eficacia ante entidades regulatorias.

• Rotylenchulus sp • Meloidogyne sp • Botrytis sp • Lasiodiplodia sp • Cilindrocarpon sp • Pestalotiopsis sp • Oidiosis • Planococcus sp • Oligonychus punicae • Etc
• Meloidogyne sp • Enraizantes • Bioestimulantes • Micorrizas • Oidiosis
• Rotylenchulus sp • Meloidogyne sp • Lasiodiplodia sp • Cilindrocarpon sp • Pestalotiopsis sp • Enraizantes • Bioestimulantes • Micorrizas • etc

Estamos a resolver cualquier duda
Es un estudio controlado que evalúa el desempeño de un producto en condiciones reales o simuladas.
Depende del tipo de cultivo y producto, pero generalmente varía entre semanas y meses.
Permiten validar el rendimiento de un producto, optimizar su uso y garantizar su impacto positivo en la producción agrícola.
Obtener un diagnóstico preciso puede ser una de las experiencias más impactantes que pueda tener. 
Copyright Laboratorio Agricola Biaster S.A.C de Seguros 2025. Todos los Derechos Reservados
WhatsApp us